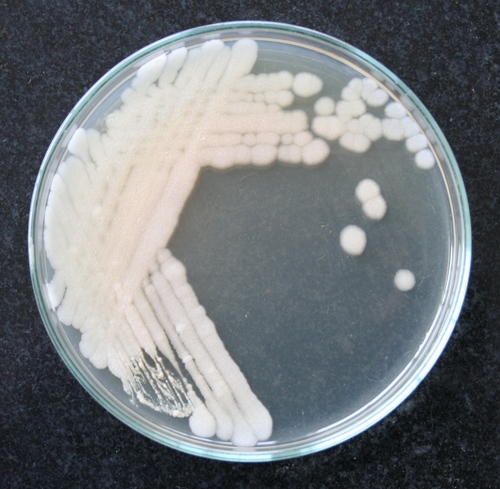

सबौराड डेक्सट्रोज आगर
नवीनतम कीमत पता करें
स्टॉक में
भुगतान की शर्तें | टेलीग्राफिक ट्रांसफर (T/T), चेक, कैश एडवांस (CA), कैश इन एडवांस (CID), कैश ऑन डिलीवरी (COD) |
मुख्य घरेलू बाज़ार | ऑल इंडिया |
प्रमाणपत्र | ISO: 9001, 2008 ISO: 13485 : 2003 ISO : 22000: 2005 HALAL CERTIFICATION CGMP CERTIFICATION FSSAI CERTIFICATION |
नमूना उपलब्ध | 1 |
नमूना नीति | हमारी नमूना नीति के बारे में जानकारी के लिए हमसे संपर्क करें |
कंपनी का विवरण
टाइटन बायोटेक ल्टड., 1994 में दिल्ली के दिल्ली में स्थापित, भारत में जैव प्रौद्योगिकी उत्पाद का टॉप निर्माता,निर्यातक,आपूर्तिकर्ता है। टाइटन बायोटेक ल्टड. ट्रेड इंडिया के सूचीबद्ध उत्पादों के सत्यापित और विश्वसनीय विक्रेताओं में से एक है। आपूर्ति और व्यापार के अपने व्यापक अनुभव के साथ, टाइटन बायोटेक ल्टड. ने उच्च गुणवत्ता आदि के साथ बाजार में अपने लिए एक प्रतिष्ठित नाम बनाया है। ग्राहक केंद्रित दृष्टिकोण पर ध्यान केंद्रित करते हुए, टाइटन बायोटेक ल्टड. की अखिल भारतीय उपस्थिति है और पूरे देश में एक विशाल उपभोक्ता आधार को पूरा करता है। टाइटन बायोटेक ल्टड. से ट्रेड इंडिया के गुणवत्ता-सुनिश्चित उत्पादों () को थोक में खरीदें।
व्यापार के प्रकार
निर्माता, निर्यातक, आपूर्तिकर्ता
कर्मचारी संख्या
5100
स्थापना
1994
कार्य दिवस
सोमवार से शनिवार
जीएसटी सं
07AAACT0078J1ZC
Certification
ISO 9001:2015
Explore in english - Sabouraud Dextrose Agar
विक्रेता विवरण

टाइटन बायोटेक ल्टड.
जीएसटी सं
07AAACT0078J1ZC
नाम
उदित सिंगला
पता
९०३ ९थ फ्लोर बिगजोस टावर, नेताजी सुभाष प्लेस, दिल्ली, दिल्ली, 110034, भारत
गलत विवरण की रिपोर्ट करें
संबंधित उत्पाद
शुद्ध पाम गुड़ पाउडर शेल्फ लाइफ: लाइफ टाइम इयर्स
Price - 440 INR
MOQ - 10 Kilograms/Kilograms
बेस्ट करूपट्टी मेकर्स
चेन्नई, Tamil Nadu
स्वीट नेचुरल क्रिस्टल व्हाइट शुगर स्वीटनर में ऑर्गेनिक और हेल्दी होते हैं
MOQ - 1000 Kilograms/Kilograms
new rawat pro & gen store
ऋषिकेश, Uttarakhand